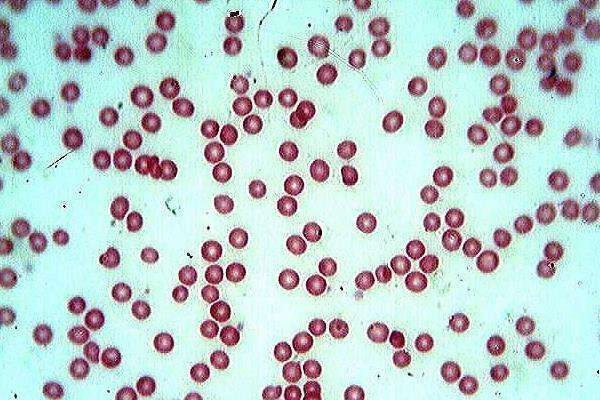

1、酵母菌的繁殖方式有芽殖、裂殖、芽裂、子囊孢子。2、芽殖:酵母菌无性繁殖主要方式。3、裂殖:是指母体通过二分裂或复分裂,分裂成大小和形状一致的新个体。4、芽裂:是指母细胞在一端出芽,然后在芽基处形成隔膜,最后分裂成子细胞。5、孢子:是指有性繁殖,酵母在一定的条件下会形成4个孢子,最后进行繁殖。

一、芽殖
1、酵母菌无性繁殖主要方式是芽殖。
2、首先会产生1个小突点,在细胞核中心体部位,水解酶在细胞壁中进行多糖分解后,细胞壁逐渐变薄,导致细胞表面会向外突起,慢慢会有小芽从其中冒出来。
3、在芽内会进入细胞质、细胞器以及部分增大和伸长的核,母细胞会给芽细胞输送核物质、线粒体、核糖体、液泡等。
4、在芽生长到正常大小后,会脱离母细胞,最后会成为1个独立的细胞。
二、裂殖
1、裂殖主要是指母体通过二分裂或复分裂,分裂成大小和形状一致的新个体。
2、部分酵母菌种类,通过细胞分裂的方式,形成两个与母体一致的子体,这个过程与细菌分裂过程相似。

三、芽裂
1、母细胞主要表现只在一端出芽,在芽基的地方会形成隔膜。
2、分裂后的子细胞主要是呈现瓶状。

四、孢子
1、在酵母菌营养不良的情况下,部分酵母可以通过有性生殖进行繁殖。
2、酵母会形成4个孢子,在环境适宜时,才会萌发。
3、假丝酵母无法进行有性繁殖。

















